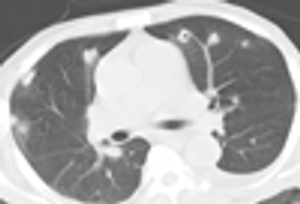

Purvesh Patel, MD
Advertisement
Articles by Purvesh Patel, MD
Advertisement
Latest Updated Articles
Woman With Fever of Unknown OriginAugust 17th 2011
Foreign-Body Aspiration in a Middle-Aged WomanApril 4th 2012
Advertisement
Advertisement
Trending on Patient Care Online
1
FDA Issues Complete Response Letter for Cingulate ADHD Drug CTx-1301
2
FDA Approves Xocova as First Oral COVID-19 Postexposure Prophylaxis Option
3
Transdermal Hormone Therapy for VMS and Cardiovascular Risk Management
4
A Multidisciplinary Approach to VMS and Cardiovascular Health
5